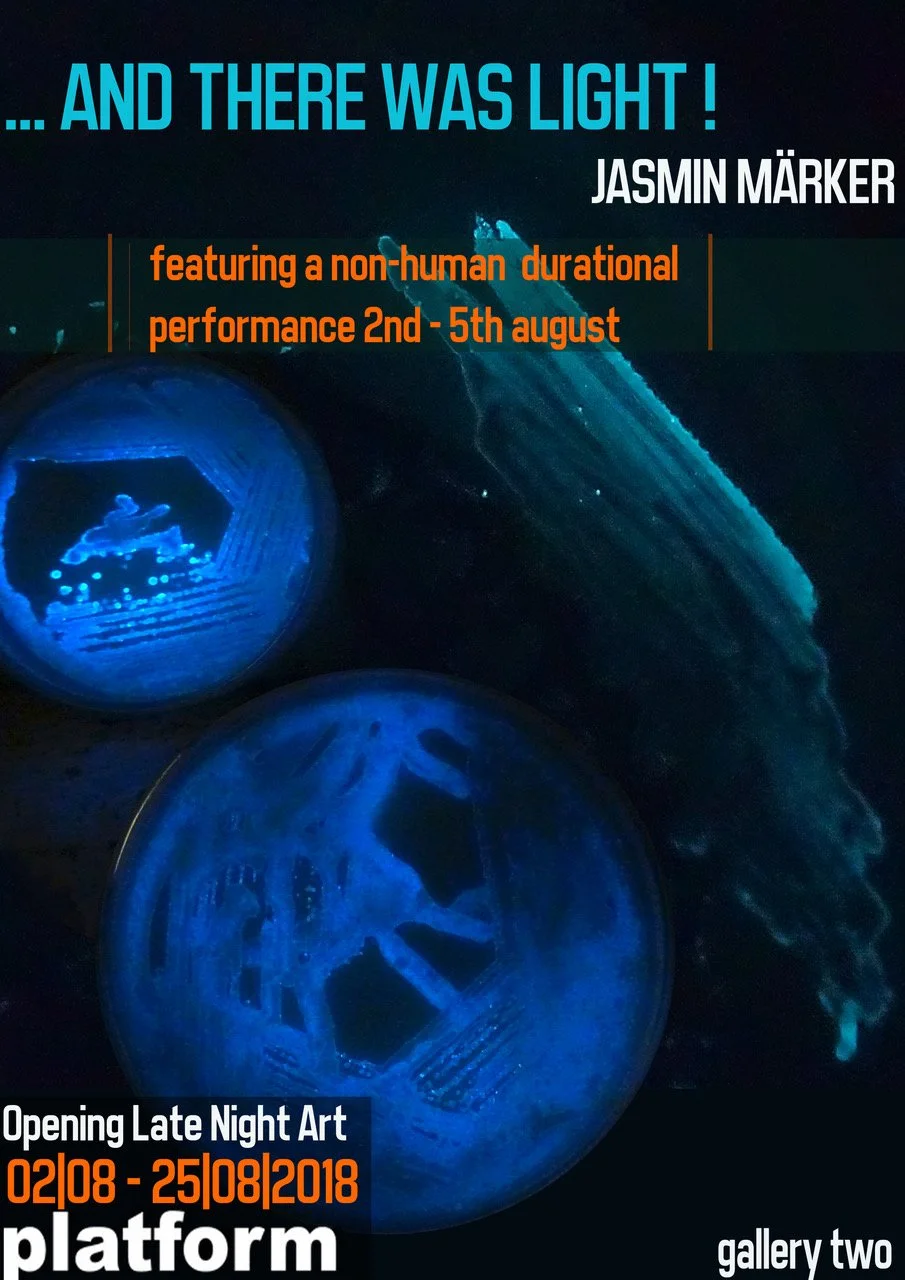

…And There Was Light!
Jasmin Märker
Featuring a non-human durational performance 2nd- 5th August.
Gallery Two
Jasmin has been sweating particularly hard during this heatwave out of worry for her non-human collaborators, namely Photobacterium Phosphorum and Pseudomonas fluorescence, the former being more fond of the mild Irish summers. Located in a studio that heats up to 30°C the artist had to resort to fridge and timer to secure the comfort of her bacteria while hoping Platform would stay cool.
… And There Was Light! is a bio-art installation suggesting a spiritual ideology, which alike others places the normally invisible at it’s centre. Playing with the bioluminescent and fluorescent properties of her collaborators the artist recreates a sacred space in Gallery Two. Identifying with the New Animism she thereby attempts to invoke empathy and solidarity with non-human nature and particularly with the trillions of invisible creatures that live around and within us.
Jasmin Märker is a Belfast-based, German born bio-artist working primarily with members of the microbial kingdoms and graduated with BA in Fine Art from University of Ulster in 2016. Engaging with a variety of bio-cultures she seeks analogies to societal cultures thereby questioning the evolution of human psychology.
Images by Simon Mills (@photosbysi)









